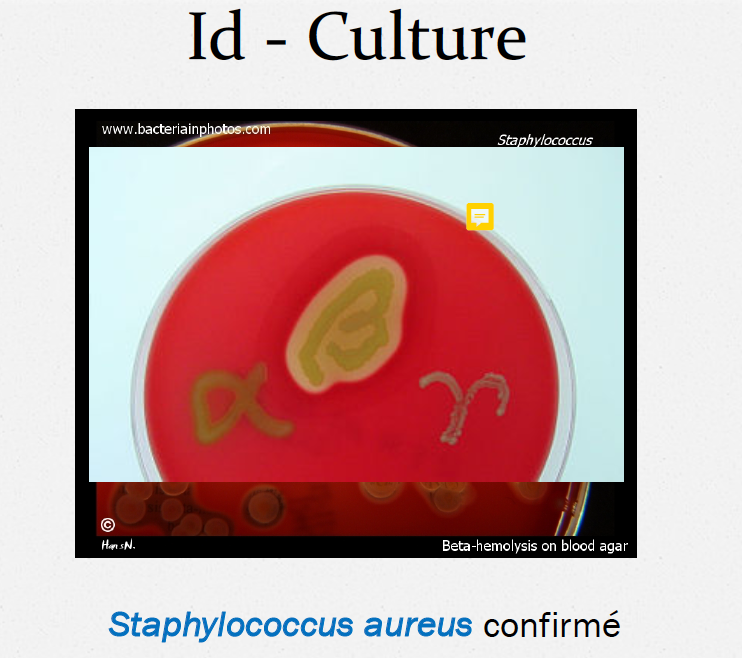

Quelle est la 2ème cause principale de décès dans le monde
Les infections
(après les maladies cardiovasculaires)
Qu’est-ce qu’a amené la découverte des antibiotiques?
Avancement majeur dans le traitement des infections et dans le contrôle des maladies infectieuses de façon durable
Qu’est-ce que permettent les antibiotiques ? (2)
Pourquoi la sélection d’antibiotiques pour traiter une infection est parfois très restreint? (2)
Quelles connaissances autres que la sensibilité des microorganismes et le spectre d’action des antibiotiques un médecin doitil maîtriser pour utiliser les antibiotiques de façon sécuritaire et efficace?
Principes de base de pharmacocinétique et de pharmacodynamique
Qu’est-ce qu’est un antibiotique?
Ce sont des molécules faisant partie de la famille des antimicrobiens qui arrêtent la croissance ou qui tuent les bactéries.
Quels sont les 4 antimicrobiens?
Avec quoi les antibiotiques interfèrent-ils?
Avec des fonctions vitales de la cellule bactérienne
Ils agissent aux différents niveaux du métabolisme microbien
Contre quoi les antibiotiques sont-ils le plus efficace?
Contre les microorganismes dont le métabolisme est actif et les formes dormantes sont peu sensibles à leur action
Quels sont les 3 groupes en lesquels se divisent les bactéries en regard de l’antibiothérapie?
Donner 3 exemples de bactéries Gram positif
Décrire la composition des bactérie Gram positif
Paroi plus épaisse riche en peptidoglycan.
Les protéines liant la pénicilline (PBP) sont des enzymes critiques dans la formation d’un peptidoglycan très dense en liaisons transpeptidiques. Ces PBP sont le site d’action des β-lactamines.

Donner 3 exemples de bactéries à Gram négatif
Décrire la compostition des bactéries Gram négatif
peptidoglycan beaucoup plus complexe et moins riche en liaisons transpeptidiques.
Les Gram négatif ont une membrane externe entourant le peptidoglycan et cette membrane contient le lipopolysacharide (LPS), un composé important dans la pathogénèse de l’infection causée par ces bactéries.

Décrire la compostition des bactéries anaérobies
Possèdent des cibles particulières au métabolisme sans oxygène et sont composées principalement de bacilles Gram négatif et de cocci Gram positif.
Donner 3 exemples de bactéries anaérobies
* Bactéries plus fastidieuses, intracellulaires ou atypiques *
Quelles deux catégories d’analyses microbiologiques guident les cliniciens dans le choix d’une antibiothérapie adéquate?
Quelles sont les 2 étapes de l’identification de l’agent pathogène lors d’analyses microbiologiques?
Décrire l’identification de l’agent pathogène par examen direct.
L’analyse en laboratoire de microbiologie s’effectue directement sur le spéciment clinique.
Il permet de mettre en évidence des bactéries
C’est un résultat préliminaire
Quelle est la principale méthode utilisée lors de l’identification d’agents pathogènes par examen direct?
La coloration de Gram

Différencier la coloration des Gram positif et des Gram négatif

Quelles sont les 2 méthodes utilisées lors de l’étape de la confirmation dans l’identification d’un agent pathogène?
Décrire l’identificaiton d’agents pathogènes par culture
Permet la confirmation de l’agent pathogène et prend environ 48h
2 atmosphères d’incubation : aérobie et anaérobie
Nommer une bactérie résistante à la oxacilline
Staphylococcus aureus résistant à la oxacilline (SARM)
** DONC ÉVITER LES ß-LACTAMINES AVEC LES SARM **